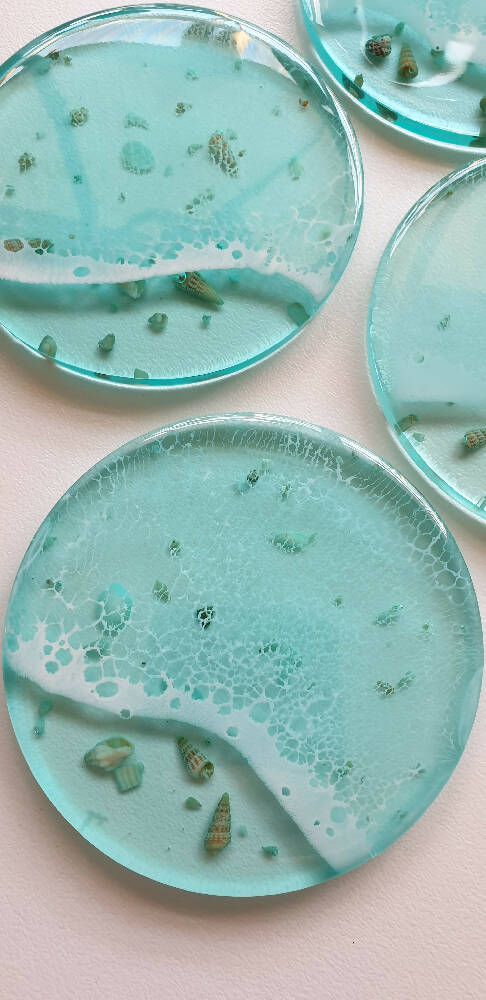
Full Resin Coasters with Shells and Frothy Wave (Set of 4)

Procrastipainter
Hi I'm Liz - the artist behind Procrastipainter.
My pieces are inspired by the beaches of the nearby surf coast. I make art in my spare time (or sometimes when I should be doing something else) from my home studio.
My handcrafted functional pieces let you have a little piece of the ocean in your own home.
Shipping Policy
Ready to ship in Ready to ship (business days)
Ships out using: Australia Post
Tracking code provided upon shipment (if applicable)
Delivery Times: Approx 1 week
Resin Art Care:
Keep your resin item out of direct sunlight to avoid UV damage.
Serving boards and washable items:
- Wash item by hand using warm, soapy water. Avoid anything abrasive to protect the surface.
- Do not soak.
- Wipe dry and allow to fully air dry before putting away.
- Avoid placing food and/or hot items on the resin area.
- The resin used for coasters makes them heat resistant for a hot coffee cup and cold drinks.
- Do not cut on the resin area.
- Not suitable for dishwasher or microwave use.
- Oil timber boards with grapeseed oil or a food grade oil every 3 months to keep it looking like new.
- Simply wipe with a damp, lint-free towel and dry with a soft, clean cloth to retain the glossy finish. Avoid anything abrasive to protect the surface.
Payment required within 3 days of purchase.
Items ship to you within 3 working days of payment clearing. I ship via Australia Post and estimate charges using their recommended postage cost which is charged by weight of product. Most items will have a tracking number. I am not liable for items lost by Australia Post.
*Note* Australia Post is experiencing very high volumes and as such delivery times cannot be guaranteed as per their tracking website.
Please contact me if you are not 100% happy with your order. I refund for damaged or not as described items only as per Australian refund laws. Purchase price of damaged item will be refunded upon it's full return.
Please note that the delivery costs will not be refunded. Returns are not accepted for change of mind.
Pick up is available from Geelong. Please send me a message should you wish to collect.